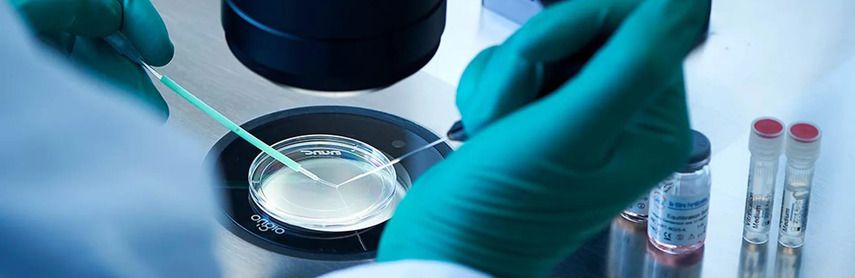
Минусы заморозки яйцеклетки

Об авторе
Доктор Меньщикова Наталья Владимирована — ведущий специалист в области репродуктивной медицины с более чем 15-летним опытом работы. Она окончила Московский государственный медицинский университет с отличием и продолжила обучение в области репродуктивного здоровья и эндокринологии.

Наталья Владимирована активно занимается научной деятельностью, является автором многочисленных публикаций в международных медицинских журналах и участником крупных конференций. Её исследования сосредоточены на инновациях в области заморозки яйцеклеток и их влиянии на репродуктивное здоровье женщин.
В своей практике доктор Меньщикова использует современные методы и технологии, стремясь предоставить своим пациентам наилучшие возможности для планирования семьи и сохранения фертильности.
Введение
Заморозка яйцеклеток, также известная как криоконсервация ооцитов, представляет собой современную медицинскую процедуру, которая позволяет женщинам сохранять свою фертильность на протяжении длительного времени. В условиях современного мира, где карьера, личное развитие и планирование семьи часто сталкиваются, заморозка яйцеклеток становится всё более востребованной.
Эта процедура даёт женщинам возможность отложить материнство на более поздний срок, сохраняя при этом качество своих яйцеклеток. В данной статье мы рассмотрим плюсы и минусы заморозки яйцеклеток, опираясь на научные данные и клинический опыт.
Цель данной статьи — предоставить исчерпывающую информацию, которая поможет женщинам принять осознанное решение о необходимости и целесообразности проведения этой процедуры.
"Заморозка яйцеклеток — это не только медицинская процедура, но и важный шаг к осознанному планированию будущего."
Плюсы заморозки яйцеклетки

Решение заморозить яйцеклетку даёт ряд значительных преимуществ, которые могут существенно повлиять на жизнь женщины. Рассмотрим основные из них:
-
Сохранение фертильности
Одним из ключевых плюсов заморозки яйцеклеток является возможность сохранения репродуктивного потенциала. С возрастом качество и количество яйцеклеток у женщин снижаются, что может затруднить зачатие в будущем.
Заморозка позволяет "законсервировать" яйцеклетки в их оптимальном состоянии, обеспечивая более высокие шансы на успешное зачатие в будущем.
"Заморозка яйцеклеток даёт женщинам возможность сохранить свою фертильность на пике, обеспечивая больше шансов на успешное зачатие в будущем."
-
Планирование семьи
Современные женщины часто сталкиваются с необходимостью балансировать между карьерой, личным развитием и желанием стать матерью. Заморозка яйцеклеток предоставляет возможность отложить материнство на более поздний срок, когда женщина будет готова к этому шагу.
Это позволяет женщинам:
- Сосредоточиться на карьерных достижениях.
- Завершить образование или профессиональное обучение.
- Найти подходящего партнёра для создания семьи.
-
Медицинские показания
Заморозка яйцеклеток может быть рекомендована женщинам, которым предстоит лечение, способное повлиять на их фертильность, например, химиотерапия или лучевая терапия. В таких случаях процедура становится важным шагом для сохранения репродуктивного здоровья.
Также заморозка может быть полезна женщинам с генетическими заболеваниями, которые хотят сохранить свои яйцеклетки до начала прогрессирования болезни.
-
Психологическое спокойствие
Знание о том, что яйцеклетки сохранены, может значительно снизить уровень стресса и тревоги, связанных с биологическими часами. Это даёт женщинам уверенность в том, что у них есть время для принятия важных жизненных решений без давления времени.
Психологическое спокойствие способствует:
- Улучшению общего эмоционального состояния.
- Снижению уровня стресса, связанного с планированием семьи.
Эти преимущества делают заморозку яйцеклеток привлекательным вариантом для многих женщин, стремящихся сохранить свою фертильность и иметь больше контроля над своим репродуктивным здоровьем.
Минусы заморозки яйцеклетки
Несмотря на многочисленные преимущества, заморозка яйцеклеток имеет и свои минусы, которые необходимо учитывать при принятии решения о проведении процедуры.
-
Финансовые затраты
Одним из значительных недостатков является высокая стоимость процедуры. Заморозка яйцеклеток включает в себя не только первоначальные расходы на саму процедуру, но и ежегодные платежи за хранение яйцеклеток.
Кроме того, в будущем могут потребоваться дополнительные расходы на процедуры экстракорпорального оплодотворения (ЭКО), если женщина решит использовать замороженные яйцеклетки.
"Финансовые аспекты заморозки яйцеклеток могут быть значительными, и важно учитывать все возможные расходы при планировании процедуры."
-
Медицинские риски
Как и любая медицинская процедура, заморозка яйцеклеток сопряжена с определёнными рисками. Гормональная стимуляция, необходимая для получения яйцеклеток, может вызвать побочные эффекты, такие как:
- Головные боли.
- Тошнота.
- Синдром гиперстимуляции яичников (СГЯ).
Также существует небольшой риск осложнений, связанных с процедурой забора яйцеклеток.
-
Эмоциональные аспекты
Процесс заморозки яйцеклеток может быть эмоционально напряжённым. Женщины могут испытывать стресс и тревогу, связанные с неопределённостью результата и возможными медицинскими рисками.
Кроме того, необходимо быть готовыми к тому, что процедура может не привести к желаемому результату, и это также может вызвать эмоциональные трудности.
-
Этические и правовые вопросы
Заморозка яйцеклеток поднимает ряд этических и правовых вопросов, которые могут варьироваться в зависимости от страны и законодательства. Например:
- Кто имеет право распоряжаться замороженными яйцеклетками в случае развода или смерти?
- Каков максимальный срок хранения яйцеклеток?
- Какие права имеют дети, рождённые с использованием замороженных яйцеклеток?
| Аспект | Плюсы | Минусы |
| Финансовые | Инвестиция в будущее | Высокая стоимость процедуры и хранения |
| Медицинские | Сохранение фертильности | Риски, связанные с гормональной стимуляцией |
| Эмоциональные | Психологическое спокойствие | Стресс и тревога, связанные с процедурой |
| Этические и правовые | Контроль над репродуктивным здоровьем | Неопределённость в правовых вопросах |
Эти минусы подчёркивают важность тщательного обдумывания и консультации с медицинскими специалистами перед принятием решения о заморозке яйцеклеток.
Процесс заморозки яйцеклетки

Процесс заморозки яйцеклеток включает несколько ключевых этапов, каждый из которых требует тщательного медицинского контроля и поддержки. Рассмотрим их подробнее:
-
Подготовка и консультация
Первым шагом является консультация с репродуктивным эндокринологом. Врач проведёт оценку общего состояния здоровья пациентки, обсудит её репродуктивные цели и объяснит все этапы процедуры.
На этом этапе также проводятся необходимые анализы и тесты, такие как:
- Анализ крови на гормоны.
- Ультразвуковое исследование яичников.
- Тесты на инфекции.
-
Гормональная стимуляция
Для стимуляции роста фолликулов, содержащих яйцеклетки, пациентке назначаются гормональные препараты. Этот процесс обычно занимает около 10-14 дней и требует регулярного мониторинга с помощью ультразвука и анализов крови.
Цель гормональной стимуляции — добиться созревания нескольких фолликулов, чтобы получить как можно больше яйцеклеток для заморозки.
-
Забор яйцеклеток
Когда фолликулы достигают необходимого размера, проводится процедура забора яйцеклеток. Она осуществляется под коротким наркозом и включает трансвагинальную пункцию фолликулов под контролем ультразвука.
Полученные яйцеклетки немедленно передаются в эмбриологическую лабораторию для дальнейшей обработки.
-
Витрификация
Современный метод заморозки яйцеклеток называется витрификацией. Это быстрая заморозка, которая предотвращает образование кристаллов льда внутри клеток, что минимизирует повреждение яйцеклеток.
Яйцеклетки помещаются в специальные контейнеры и хранятся в жидком азоте при температуре -196°C.
-
Хранение яйцеклеток
Замороженные яйцеклетки могут храниться в течение многих лет без потери качества. Однако важно учитывать, что за хранение взимается ежегодная плата.
Пациентка может использовать свои яйцеклетки в будущем, когда решит, что готова к беременности. Для этого яйцеклетки размораживаются и используются в процедуре ЭКО.
Успешные истории и статистика

Заморозка яйцеклеток уже помогла многим женщинам по всему миру сохранить свою фертильность и стать матерями в подходящее для них время. Рассмотрим некоторые успешные истории и статистические данные, которые подтверждают эффективность этой процедуры.
Успешные истории
Многие женщины, решившиеся на заморозку яйцеклеток, успешно использовали их в будущем для достижения беременности. Вот несколько примеров:
"Анна, 38 лет, заморозила свои яйцеклетки в 32 года, когда узнала о необходимости химиотерапии. Через несколько лет после успешного лечения она использовала свои замороженные яйцеклетки и родила здорового ребёнка."
"Мария, 42 года, всегда мечтала о карьере и семье. Она заморозила свои яйцеклетки в 35 лет, чтобы иметь возможность сосредоточиться на профессиональном развитии. В 40 лет она решила стать матерью и успешно забеременела с помощью своих замороженных яйцеклеток."
Статистика эффективности
Статистические данные показывают, что заморозка яйцеклеток является эффективным методом сохранения фертильности. Согласно исследованиям, вероятность успешного зачатия с использованием замороженных яйцеклеток может быть сравнима с использованием свежих яйцеклеток, особенно если яйцеклетки были заморожены в молодом возрасте.
Некоторые ключевые статистические данные:
- Вероятность успешного зачатия с использованием замороженных яйцеклеток составляет около 40-60%, в зависимости от возраста женщины на момент заморозки.
- Успешность процедуры значительно выше, если яйцеклетки были заморожены до 35 лет.
- Современные методы витрификации позволяют сохранять до 90% жизнеспособности яйцеклеток после разморозки.
| Возраст на момент заморозки | Вероятность успешного зачатия |
| < 30 лет | 50-60% |
| 30-35 лет | 40-50% |
| > 35 лет | 30-40% |
Эти данные свидетельствуют о том, что заморозка яйцеклеток может быть эффективным решением для женщин, желающих сохранить свою фертильность. Однако важно помнить, что каждый случай уникален, и успех процедуры зависит от множества факторов, включая возраст, состояние здоровья и качество яйцеклеток.
Альтернативные методы сохранения фертильности

Заморозка яйцеклеток — это не единственный метод сохранения фертильности. Существуют и другие подходы, которые могут быть подходящими в зависимости от индивидуальных обстоятельств и предпочтений. Рассмотрим основные альтернативные методы:
Заморозка эмбрионов
Заморозка эмбрионов является одним из наиболее распространённых методов сохранения фертильности. В этом случае яйцеклетки оплодотворяются спермой партнёра или донора перед заморозкой.
Плюсы:
- Высокая вероятность успешного зачатия, так как эмбрионы уже оплодотворены.
- Возможность генетического тестирования эмбрионов перед имплантацией.
Минусы:
- Необходимость наличия партнёра или донора спермы.
- Этические и правовые вопросы, связанные с хранением и использованием эмбрионов.
Консервация ткани яичников
Консервация ткани яичников — это метод, при котором часть ткани яичника удаляется и замораживается для последующего использования. Этот метод может быть полезен для женщин, которым предстоит лечение, способное повлиять на их фертильность.
Плюсы:
- Возможность восстановления естественной функции яичников после трансплантации.
- Сохранение большого количества яйцеклеток, особенно у молодых женщин.
Минусы:
- Экспериментальный характер метода и ограниченная доступность.
- Риск повторного возникновения заболевания при трансплантации ткани у пациенток с онкологией.
Использование донорских яйцеклеток
Если собственные яйцеклетки не могут быть использованы, возможна опция использования донорских яйцеклеток. Этот метод позволяет женщинам, столкнувшимся с проблемами фертильности, стать матерями.
Плюсы:
- Высокая вероятность успешного зачатия с использованием яйцеклеток молодых и здоровых доноров.
- Возможность выбора донора с определёнными характеристиками.
Минусы:
- Этические и эмоциональные аспекты, связанные с использованием донорских яйцеклеток.
- Высокая стоимость процедуры.
"Альтернативные методы сохранения фертильности предоставляют женщинам дополнительные возможности для планирования семьи и реализации своих репродуктивных целей."
Заключение
Заморозка яйцеклеток представляет собой значительный шаг вперед в области репродуктивной медицины, предоставляя женщинам возможность сохранить свою фертильность и планировать семью на своих условиях. Этот метод имеет как свои преимущества, так и недостатки, которые необходимо тщательно учитывать при принятии решения.
Плюсы заморозки яйцеклеток включают сохранение фертильности, возможность отложить материнство, медицинские показания и психологическое спокойствие. Однако, минусы, такие как финансовые затраты, медицинские риски, эмоциональные аспекты и этические вопросы, также требуют внимательного рассмотрения.
Процесс заморозки яйцеклеток требует тщательного планирования и медицинского контроля на каждом этапе. Успешные истории и статистика свидетельствуют о том, что этот метод может быть эффективным решением для многих женщин.
Альтернативные методы сохранения фертильности, такие как заморозка эмбрионов, консервация ткани яичников и использование донорских яйцеклеток, также заслуживают внимания. Выбор метода зависит от индивидуальных обстоятельств и предпочтений.
"Заморозка яйцеклеток — это не только медицинская процедура, но и важный шаг к осознанному планированию будущего, который может изменить жизнь женщины."


